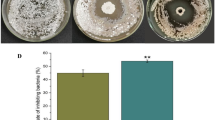

Abstract
The pathogenicity of 10 bacterial isolates was investigated on potato, radish, carrot and beet, including sensitivity and pathogen control efficacy. The isolates were identified by morphological, biochemical and molecular methods. All isolates were pathogenic on radish, carrot, and beet, and were highly virulent on potato. Although the isolates were obtained from different locations in the El Fuerte Valley (Sinaloa, Mexico), they were similar in their morphological, physiological and biochemical characteristics. Sequences of the 16S rRNA gene obtained by PCR were identical for all isolates. These results indicate that the bacterial isolates from potato scabby tissue belong to S. acidiscabies. Furthermore, the effectiveness of fluazinam, both in vitro and under greenhouse and field conditions, represents a possible
option for chemical control of potato common scab disease. While our results suggest that spraying at seeding is effective in controlling common scab, future studies to combine this treatment with seed dressing before planting will be conducted to determine if there is an increase in disease control.
Resumen
Se investigó la patogenicidad de diez aislamientos bacterianos en papa, rábano, sanahoria y betabel, incluyendo la sensibilidad y la eficacia de control del patógeno. Se identificó a los aislamientos mediante métodos morfológicos, bioquímicos, y moleculares. Todos los aislamientos fueron patogénicos en rábano, zanahoria y betabel, y fueron altamente virulentos en papa. Aunque los aislamientos se obtuvieron de diferentes lugares en el Valle del fuerte (Sinaloa, México) fueron similares en sus características morflógicas, fisiológicas y bioquímicas. Las secuencias del gen 16S rRNA obtenidas por PCR fueron idénticas para todos los aislamientos. Estos resultados indican que los aislamientos bacterianos de tejido de la roña en papa pertenecen a S. acidiscabies. Aún más, la efectividad de fluazinam, tanto in vitro como bajo condiciones de invernadero y campo, representa una opción posible para el control químico de la enfermedad de la roña común en papa. Mientras que nuestros resultados sugieren que la aspersión en la siembra es efectiva en el control de la roña común, se conducirán estudios a futuro para combinar este tratamiento con cubrimiento a la semilla antes de la siembra para determinar si hay un aumento en el control de la enfermedad.
Similar content being viewed by others
Avoid common mistakes on your manuscript.
Introduction
Potato productivity is hindered by numerous diseases caused by bacteria (Kirk 2015). After potato late blight and bacterial soft rot, potato common scab (PCS) is one of the main concerns for farmers worldwide, since it reduces the quality of tubers and primarily results in skin blemishes that render them unacceptable for seed potato production, fresh markets and processing (Loria et al. 1997; Wanner and Kirk 2015). The disease also affects other root crops including radish, beet, carrot, turnip and sweet potato, and can cause considerable economic loss (Wanner 2004). There is no adequate means to consistently manage PCS to date, despite the fact that it is one of the earliest-described potato diseases and it has been rated among the top five diseases by potato seed producers in the USA (Slack 1991). In 2002, approximately 82 % of Canadian potato fields were affected by PCS, at a cost of ca. $100/ha (Hill and Lazarovits 2005).
PCS has occurred in recent growing seasons in Sinaloa, Mexico, and represents a serious threat to the 15,000 ha of potato planted during the fall-winter growing season. S. scabies was previously implicated in PCS in the southern Sonora (Leyva-Mir et al. 2014) and in the Guasave Valley in northern Sinaloa (Rete-Corral 2011); in these regions, all potato varieties are susceptible to the disease and considerable amounts of produce are rejected for both fresh market consumption and the potato chip industry. The tubers display superficial brown corky lesions, which may coalesce and cover 50 % of the surface area of progeny tubers (Fig. 1a).
PCS is caused by soil-inhabiting gram-positive filamentous bacteria belonging to the genus Streptomyces (Loria et al. 2006). This pathogen may over-winter either in soil or on the surface of seed tubers, thereby serving as next year’s inoculum source. For this reason, healthy seed tubers are vital to sustain the continued supply of potatoes between seasons (Kirk 2015). Pathogen inoculum density plays an important role in the incidence of PCS disease. However, the incidence and development of symptoms also depends on the susceptibility of the potato cultivar, environmental conditions, infection date or virulence of the Streptomyces species (Cullen and Lees 2007).
At least 13 different Streptomyces species can cause PCS worldwide (Bouchek-Mechiche et al. 2000; Doering-Saad et al. 1992; Kreuze et al. 1999; Loria et al. 1997; Miyajima et al. 1998; Wanner and Kirk 2015). S. scabies is recognized as the most widely distributed species, followed by S. turgidiscabies and S. acidiscabies (Lerat et al. 2009). Several Streptomyces species have been reported to infect potato tubers in North America. Specifically, S. scabies was the most abundant species from the mid-plains eastward and S. europaeiscabiei was more common in the west (Wanner 2007; Wanner 2009).
The identification and taxonomy of Streptomyces spp. has been based on morphological and biochemical characteristics combined with thaxtomin production, as well as in vitro and in vivo pathogenicity tests (Faucher et al. 1995; Wanner 2004). However, DNA sequence relatedness, 16S ribosomal DNA (rDNA) sequences, and DNA-DNA hybridization have also been used successfully for species-level identification (Bouchek-Mechiche et al. 2000; Healy and Lambert 1991; Kreuze et al. 1999; Lehtonen et al. 2004; Park et al. 2003; Song et al. 2004; Takeuchi et al. 1996). Thus, the sequence of the 16S rRNA gene in combination with the physiological, biochemical, and the phenotypic characteristics as well as the pathogenicity to carrot, beet and radish were used to identify the species of Streptomyces involved in common scab of potato in the present study.
Previous studies have identified S. scabies infections in carrots in the Netherlands and Canada (Goyer and Beaulieu 1997; Janse 1998). Furthermore, the pathogenicity of two S. caviscabies isolates and one S. acidiscabies isolate has been determined on potato, carrot, beet, and radish (Goyer and Beaulieu 1997). Sixty-one Streptomyces isolates from scabby potato plants were shown to differ in pathogenicity and virulence on radish (Wanner 2004). Various biocidal products have been used around the world to chemically manage Streptomyces implicated in potato scab (Davis and Callihan 1971; De and Sengupta 1993; Hooker 1981; Mishra et al. 1991; Singh and Soni 1987). However, some of them are not currently used to manage common scab due to the withdrawal of product registration such as formaldehyde, urea formaldehyde, and organomercuric compounds (Wilson et al. 1999), or for their hazardous effects on growers and field workers, e.g. pentachloronitrobenzene (PCNB; Locci 1994). Nevertheless, fluazinam and mancozeb have both proven effective as potato seed dressing against PCS under field conditions (Wilson et al. 1999). Additionally, the products Capitan, Ridomil and Rizolex have been observed to reduce the scab severity index caused by S. scabies under field conditions in Egypt (Hosny et al. 2014).
The symptomatology of PCS in the El Fuerte Valley in northern Sinaloa differs from the symptomatology associated with S. scabies, which has been reported as the causal agent of the disease in different potato growing areas of the southern Sonora (Mexico). Currently, all potato varieties grown in Sinaloa are susceptible to PCS disease. Furthermore, the pathogenicity of the isolates on vegetables such as radish, beet and carrot is unknown. Although there is information for fungicide effectiveness on other Streptomyces species that cause PCS on potato in other parts of the world (Wilson et al. 1999; Pung and Cross 2000), their efficacy has not yet been evaluated in Sinaloa. Therefore, the objectives of this study were to: a) identify the species of Streptomyces associated with PCS in the El Fuerte Valley; b) determine the pathogenicity of the isolates on potato, radish, carrot, and beet; and c) determine the sensitivity of the pathogen to three fungicides in vitro and to test their effectiveness in controlling the disease under greenhouse and field conditions.
Materials and Methods
Sample Collection and Streptomyces Isolation from Potato Tubers
Potato tubers with superficial brown coalescing corky lesions were collected from ten commercial fields in the El Fuerte Valley in northern Sinaloa (Mexico) during the 2012–2013 growing seasons (Table 1) and processed as previously described for bacteria isolation (Schaad et al. 2001). The isolates were purified by serial dilution to obtain single colonies in water agar. The isolates were maintained as spore suspensions in 20 % glycerol at −20 °C for subsequent studies.
Physiological and Biochemical Characterization
Phenotypic characteristics such as the spore mass and reverse mycelium color were determined on ISP 2, 3, 4 and 5 media, whereas pigment production was resolved on ISP 6 medium (Shirling and Gottlieb 1966). Spore chain morphology and spore ornamentation were observed on inorganic salts starch agar (ISP medium 4); the utilization of carbon compounds and the minimum pH that allowed growth were determined as previously described (Lambert and Loria 1989b).
Pathogenicity Tests on Potato, Radish, Carrot and Beet
The isolates were tested for pathogenicity based on the method of Wanner (2007) with some modifications. Specifically, a 250-ml Erlenmeyer flask containing 50 ml of YME broth was inoculated with a 1.5-cm diameter disc containing water agar with active mycelium growth, as well as the visibly densest spore growth of 10 Streptomyces isolates from 8-day-old pure isolates. Cultures were grown for 3 days with shaking (160 rpm) at 28 °C. One hundred ml of the 3-day culture and 100 ml of sterile 2× Say’s solution (40 g sucrose, 2.4 g asparagine, 1.2 g K2HPO4, 20 g yeast extract in 1 l of sterile distilled water) were added to high density polyethylene autoclavable nylon bags containing 2100 cm3 of sterile vermiculite. Inoculated vermiculite was incubated for 15 days at 28 °C and was mixed by shaking the bags every day during the incubation period. After 15 days, a 10 cm3 sample of the vermiculite culture was removed and agitated in 100 ml of sterile distilled water. Triplicate 200-μl dilutions (10−4, 10−5, 10−6) were plated on water agar. Plates were incubated at 28 °C for 3 days and colonies were counted to ensure that only Streptomyces was visible in the inoculum, and also to estimate inoculum concentration.
Thirty-five-cm plastic pots were partly filled with 5300 cm3 of a sterile mixture of clay:loam:sand (with a respective ratio of 28.1:27:44.9) at pH 7.0. Vermiculite inoculum (700 cm3) containing 1.7–3.1 × 1011 CFU cm−3 of Streptomyces was added to the potting mix and thoroughly mixed. Certified potato seed mini-tubers var. Atlantic (susceptible to common scab) produced from in vitro tissue cuttings were surface sterilized with 0.5 % NaClO for 5 min and rinsed with distilled water before planting in the artificially infested soil. Radish seed (Raphanus sativus var. Champion), carrot (Daucus carota var. Nantes Mexican Strain) and beet (Beta vulgaris var. Detroit Dark Red ) were surface sterilized (0.25 % bleach for 5 min), rinsed three times in sterile distilled water, and placed in a moist chamber at 25 °C during 14 days for germination; the seedlings were subsequently transplanted to the artificially infested soil. The treatments were arranged in a completely randomized block design. One potato seed mini-tuber was planted per pot with four replications. In root crops, five 14-day-old seedlings were transplanted per pot for each radish, carrot and beet. Each isolate-plant combination was replicated 4 times (i.e. four pots with 5 plants per isolate). Uninfected controls were included in each pathogenicity test. Soil temperature during the greenhouse experiments ranged from 7 to 30 °C. Inoculated and non-inoculated plants were fertilized once per week with Miracle-Gro fertilizer (The Scotts Company LLC; Marysville, Ohio USA) following the manufacturer’s recommendations, and were watered as needed. Potatoes were harvested 12 weeks after planting. Radish, beets and carrots were harvested 7, 8 and 10 weeks after planting, respectively. The percentage of area covered by scab was visually estimated according to Bjor and Roer (1980) in 5 plants in each replicate of different root crops at harvest time. At the end of the experimental period, bacteria were re-isolated from the different inoculated plants and their identity was confirmed using the morphological and biochemical characteristics of the colonies.
Molecular Characterization
DNA Extraction
Total bacterial DNA from 10 Streptomyces isolates causing PCS was extracted using a modified version of the protocol described by Chen and Kuo (1993). Briefly, single colonies grown on Czapek medium were transferred to 5 ml of CRM broth and cultures were grown by shaking at 150 rpm and 30 °C. After 24 to 48 h, the cultures were centrifuged at 14,400 g for 2 min, the supernatant was removed and the pellet was suspended in 200 μl of lysis buffer (40 mM Tris-HCl pH 8, 20 mM sodium-acetate, 1 mM EDTA, 1 % SDS) by vigorous pipetting. RNA was removed by adding 30 μl of RNase A in the lysis step. After incubation for 30 min at 37 °C, 66 μl of 5 M NaCl solution was added and mixed well, and the viscous mixture was centrifuged at 14,400 g for 10 min at 4 °C. The clear supernatant was transferred to a new tube and an equal volume of chloroform:isoamyl alcohol (24:1) was added. The mixture was centrifuged at 14,400 g for 10 min, and the aqueous phase was transferred to a new tube and an equal volume of 100 % isopropanol was added for DNA precipitation. The DNA was collected by centrifugation at 4400 g for 8 min, washed twice with 70 % ethanol, dried in a speed-vac, and re-suspended in 30 μl of nuclease-free water. The DNA was stored at −20 °C until further use.
PCR Amplification and Sequencing
The actinomycetes-specific primer pair Sm6F (5´-GGTGGCGAAGGCGGA-3´) and Sm5R (5´-GAACTGAGACCGGCTTTTTGA-3´) was first used to amplify a 620 bp fragment from the 16S rRNA gene, as previously described (Monciardini et al. 2002). Afterwards a 1531 bp fragment was amplified from DNA of four representative Streptomyces isolates by PCR using universal bacterial 16S rDNA primers 16s1F (5´-CATTCACGGAGAGTTTGATCC-3′) and 16s1R (5′-AGAAAGGAGGTGATCCAGCC-3′) (Bukhalid et al. 2002). PCR amplification of the Streptomyces isolates was conducted in an automatic thermocycler (C1000 Thermal Cycler, BioRad, USA), in a final volume of 25 μL containing: 1.0 and 2.5 units of Taq DNA polymerase for Sm6F/Sm5R and 16s1F/16s1R primers, respectively (Invitrogen Life Technologies, Brazil); 200 mM of each dNTP; 0.4 pmol/mL and 0.5 pmol/mL of SM6F/Sm5R and 16s1F/16s1R primers, respectively; and 100 ng of DNA. PCR products (10 μl) were loaded on 1 % agarose gels for electrophoresis, and visualized by staining with ethidium bromide and UV illumination. PCR products were purified with the Wizard SV Gel and PCR Clean-Up System kits (Promega Corporation, USA) according to the manufacturer’s instructions. The products were sequenced in an ABI PRISM 377 sequencer using the terminator dye cycle sequencing kit (Applied Biosystems; USA). The 16S rDNA fragment was bidirectionally sequenced.
DNA Sequence and Phylogenetic Analysis
Sequences obtained in the present work were compared with non-redundant databases from the Genbank site of the National Center for Biotechnology Information (NCBI; http://www.ncbi.nlm.nih.gov/) using the BLAST-N program and the Mega blast algorithm. The Streptomyces acidiscabies sequences of this study were submitted to the Genbank database (Table 1, Fig. 2).
Sequence and phylogenetic analyses were performed using the Molecular Evolutionary Genetics Analysis software (MEGA 6; Tamura et al. 2013). The Streptomyces acidiscabies 16S ribosomal RNA sequences and homologous sequences were downloaded from the NCBI database and aligned with the queries using MUSCLE multiple sequence alignment software (Edgar 2004) implemented in MEGA 6. Matrix pairwise comparisons of nucleic acid sequences were corrected for multiple base substitutions with Kimura’s two-parameter method (1980), and phylogenetic trees were constructed using the neighbor-joining method (Saitou and Nei 1987). A bootstrap confidence analysis was performed with 1000 replicates to determine the reliability of the obtained distance tree topologies (Felsenstein 1985).
Chemical Control
Effect of Fungicides on S. acidiscabies Growth in Vitro
Two S. acidiscabies isolates (V2–1 and V2–8) were tested for sensitivity to three fungicides in vitro. The fungicides used include Flonex MZ 400 (mancozeb; 33 % of a coordination product of zinc ion and manganese ethylene bisdithiocarbamate; Grupo Bioquimico Mexicano, S.A. de C.V.), Shogun 500WF (40.4 % fluazinam; Syngenta Corporativo, Mexico, S.A. de C.V.), and Busan 30 WB (30 % benzothiazole; Buckman Laboratories, Mexico S.A. de C.V.). Fungicide doses were 0.0, 10, 100, 1000 and 10,000 ppm. The suspension concentrations of the two isolates were adjusted to 7 × 106 CFU ml−1 and 200 μl of bacterial suspension was spread uniformly on water-agar media. Filter paper discs (1.5 cm in diameter) were soaked individually with 70 μl of fungicide solution and placed in the center of the petri plates immediately after spreading the isolates on the medium. The discs were then incubated at 28 °C for 14 days. The treatments were arranged in a completely randomized design with four replicates (four petri plates). The fungicide sensitivity of the two S. acidiscabies isolates was determined by measuring the halo of bacterial growth inhibition (in cm) from the edge of the filter paper; and then the sensitivity of two strains of the pathogen to the fungicides was calculated based on the 50 % inhibition concentration (IC50).
Evaluation of the Fungicidal Effect on PCS Caused by S. acidiscabies under Greenhouse Conditions
Two doses of the fungicides described above were tested against S. acidiscabies under greenhouse conditions. Plastic pots (30 cm in diameter, with 7.0 kg of soil) were filled with soil artificially inoculated with S. acidiscabies isolate V2–8; The procedures to produce the inoculum and the potting mix infestation were the same as in the experiments conducted to determine the pathogenicity of S. acidiscabies isolates to potato, carrot, radish and beet. One disinfested mini-tuber seed was placed in each pot. Three fungicide applications were performed to simulate irrigation of the plants. The first application was performed during planting and the other two at 20-day intervals after the first application. Treatment efficacy was determined by visually estimating the percent of scabby surface area in the daughter tubers at 84 days after seeding following procedures previously described (Bjor and Roer 1980). The treatments were arranged in a completely randomized design with four replicates, and the experiment was repeated once.
Evaluation of the Fungicidal Effect in Managing PCS Caused by S. acidiscabies under Field Conditions
Field experiments were established in an experimental station located in northern Sinaloa during the second and third weeks of December 2013 and December 2014. Previous growing seasons at the experimental site have shown a high incidence of common scab. Additionally, seeds from the tuber var. Fianna (highly susceptible to common scab) used in this experiment displayed light scab symptoms of the disease. The soil type was characterized as clay-loam (pH 7.2) which is representative of potato producing soils in northern Sinaloa. Based on the results of soil testing, the experimental plots were fertilized as follows: 400 kg/ha of 17–17-17 in the row before planting, and 300 kg/ha of 46–00-00 as a prehill top-dress application 30 days after planting. The experiments were established in a randomized complete block design with four replicates and four treatments (three fungicides and an untreated control). The experimental unit consisted of four 10-m-long rows with a 1-m alley between blocks, and one empty row between plots to minimize interplot spray interference. Tuber seeds were 25 cm apart in the rows, and the distance between rows was 90 cm. The fungicides were applied immediately after placing the seed tubers on the ground, and were sprayed in a 40-cm-wide band using a previously calibrated backpack sprayer. Next, the tuber seeds were covered with soil and rows were built using specialized equipment hooked to a tractor. The mancozeb, fluazinam and benzothiazole fungicides were used as recommended by the manufacturers. At harvest time, a random sample of 50 daughter tubers was taken from each plot. The tubers were washed and examined to evaluate the percentage of tuber area covered by symptoms of common scab as described by Bjor and Roer (1980). The symptoms of progeny tubers in the experimental plots resembled those induced by S. acidiscabies in artificial inoculations under greenhouse and natural conditions in commercial potato fields in northern Sinaloa.
Statistical Analyses of Data
Data from the in vitro inhibition tests of fluazinam, mancozeb, and benzothiazole at doses of 0.0, 10, 100, 1000, and 10,000 ppm to S. acidiscabies (strains V2–1 and V2–8) were analyzed using the Kruskal-Wallis non-parametric analysis. Mean comparison of growth inhibition was performed applying the Conover (1999) test. To calculate the IC50, equivalent to the EC50 (Koenraad et al. 2001), a logistics model of 4 parameters (Sebaugh 2011) was used with the procedure of the Nlin and Marquardt method. Data on the percentage of area covered by common scab in potato tuber, radish, carrot and beet trials in pots were also subject to a non-parametric analysis of variance of Kruskal-Wallis with the NPAR1WAY procedure and the Wilcoxon test. Mean comparison was performed using procedures previously described (Conover 1999). In the field experiments related to scab management with the above-mentioned fungicides data on the percentage of area covered by scab were transformed to arc sin values as previously described (Gomez and Gomez 1984) and the data were analyzed using ANOVA and the mean separation following Tukey’s test, as previously described (Little and Hills 1973). All experiments were conducted twice. Results from the two field experiments are shown because the analysis of variance reflected a significant interaction between experiments. All statistical analyses were performed using SAS V. 9.2 (Statistical Analysis System, Institute, Inc. Cary, NC).
Results
Morphological, Physiological and Biochemical Characteristics of Streptomyces Sp.
A total of 30 Streptomyces sp. isolates were obtained during the sampling period from different locations within the El Fuerte Valley in Northern Sinaloa. All isolates produced white spore color on ISP 3, 4 and 5 media (Shirling and Gottlieb 1966); the reverse mycelium color on ISP 2, 3, 4 and 5 media was brown, but no reverse color was shown in the ISP medium 6 (Shirling and Gottlieb 1966). The spore chain was flexuous and the spore wall was smooth. All isolates utilized L-arabinose, D-Fructose, D-Glucose, D-Manitol, Rhamnose, Sucrose, D-Xylose, and i-Inositol, but no Raffinose was used. Also, they showed minimum growth at pH 4.0 on the ISP medium 4. The isolates were very similar for all characteristics; therefore, ten of the isolates causing common scab were selected for further study. These ten isolates were identical to the S. acidiscabies strain type reported by Lambert and Loria (1989b) (Table 2).
Molecular Analysis of Streptomyces Sp.
PCR amplification of the 10 isolates using the primers Sm6F/Sm5R and 16s1F/16s1R resulted in a 620 and 1531 bp PCR products, respectively. Sequencing of the 10 (SM6F/Sm5R) and four (16s1F/16s1R) bacterial isolate amplicons revealed a 100 % identity among all of them. Comparison of the 620 and 1531 bp PCR fragments to Genbank databases indicated that it is 100 % identical to several S. acidiscabies strains from diverse origins. The four Streptomyces 16s1F/16s1R sequences were used for 16S rDNA phylogenetic analysis. These isolate sequences clustered with typical S. acidiscabies strains from two regions of the world with 100 % of the bootstrap replicates and were more closely related to S. coelicolor, S. lincolnensis and S. coralus in terms of distance (Fig. 2). Overall, these results strongly suggest that the ten Streptomyces sp. isolates in this study belong to S. acidiscabies.
Pathogenicity Tests
All isolates were found to be pathogenic on radish, carrot, and beet, and were generally highly virulent on potato. Tuber lesions produced after inoculation by each isolate were identical to those from scab lesions observed on field-grown tubers (Fig. 1b). The percentage of tuber surface covered by scab in progeny tubers harvested from soil artificially infested with seven isolates (V2–1, V2–2, V2–3, V2–4, V2–6, V2–8, and V2–9) ranged from 83.5 % (V2–4) to 99.0 % (V2–9), with no significant differences (P ≤ 0.05) among these isolates; whereas V2–5, V2–7 and V2–10 caused a 48.8, 88.3 and 67.8 % of scab respectively with no significant differences among these isolates (P ≤ 0.05). The ten isolates induced scab on radish bulbs grown in infested soil; although no significant differences in pathogenicity were revealed (P ≤ 0.05), values ranged from 36.1 % (V2–5) to 78.3 % (V2–3). Eight out of ten isolates were pathogenic in carrot, with infected roots displaying constrictions and reduced growth; there was a significant difference among pathogenic isolates (P ≤ 0.05), with root coverage by scab ranging from 2.8 % (V2–7) to 39.2 % (V2–10). All ten isolates were pathogenic to beets, but were different in virulence since the scab on bulbs ranged from 7.4 % (V2–2) to 54.4 % (V2–9) with significant differences between these isolates; the other isolates besides V2–2 and V2–9 were moderately virulent (causing 10.5–46.6 % scab) with significant differences among them (Table 3).
Effect of Fungicides on S. acidiscabies Growth in Vitro
The IC50 values of mancozeb ranged from 1024 to 1241 ppm, whereas fluazinam varied from 18.5 to 56.0 ppm. Since benzothiazole was ineffective in vitro, in concentrations of 10, 100 and 1000 ppm, the statistical procedures used in the data analysis, did not show IC50 for in vitro inhibition of strains V2–1 and V2–8 of S. acidiscabies in two experiments (Table 4).
Effect of Fungicides in the Control of PCS Caused by S. acidiscabies under Greenhouse Conditions
The occurrence of scab in progeny tubers harvested from plants grown in artificially infested soil with isolate V2–8, in the absence of fungicide, was 49.0 % in experiment 2013 and 53.2 % in experiment 2014. These values were significantly higher (P ≤ 0.05) than the percent scab observed in tubers harvested from plants treated with fungicides. Scab symptoms in tubers treated with 0.22 L/ha of fluazinam were either low (0.6 %; experiment 1) or absent (experiment 2). Tubers treated with a lower dose (0.14 L/ha) of the same fungicide displayed a higher amount of scab in both experiments (particularly in experiment 2). The percent of scab in progeny tubers harvested from plants treated with benzothiazole (2.59 and 1.83 L/ha) and mancozeb (2.95 and 2.22 L/ha) ranged from 13.7–22.5 % in experiment 1. In experiment 2, the scabby surface shown by tubers applied with the same treatments varied from 10 to 35 % (Table 5).
Effect of Fungicides in the Control of PCS Caused by S. acidiscabies under Field Conditions
Scab occurrence in daughter tubers from plots treated with fluazinam, mancozeb and benzothiazole at planting (in the furrow) varied between 3.7–19.7 % in experiment 1, and from 5.2–21.0 % in experiment 2. Scab severity of tubers harvested from the non-treated plots was 30.7 and 24 % in experiments 1 and 2, respectively. No significant differences (P ≤ 0.05) were found among treatments, except in experiment 1 where the percent of scab in tubers from plots treated with fluazinam was 3.7 %; the percent of scab in control plots was 30.7 % (Table 6).
Discussion
The ten Streptomyces isolates included in the present study were nearly identical in their morphological, biochemical, and physiological characteristics (Lambert and Loria 1989a, b; Schaad et al. 2001). Additionally, the sequence of the 16S rRNA gene was 100 % identical among all Streptomyces strains. These results suggest that the ten strains from Sinaloa are derived from a common source, as previously stated for other Streptomyces species.
The characteristics of our ten Streptomyces sp. isolates obtained from scabby tubers in commercial fields in northern Sinaloa differ from those of S. scabies, which was previously reported as the causal agent of PCS in the Guasave (Sinaloa) and Mayo (Sonora) Valleys (Leyva-Mir et al. 2014; Rete-Corral 2011). In contrast, our isolates are similar to S. acidiscabies regarding colony morphology (e.g. flexuous spore chains and white spore masses), molecular analysis, and the fact that raffinose is not used as the sole carbon source (Lambert and Loria 1989b; Takeuchi et al. 1996). In previous molecular studies, S. acidiscabies was found in the rhizosphere of potato from several locations in northern Sinaloa (Rete-Corral 2011). Since S. acidiscabies is usually transmitted by infected seed tubers (Manzer et al. 1977), it may be introduced to Sinaloa via infected tuber seeds from different potato growing areas of Mexico. This demonstrates the need to incorporate innovative strategies in seed certification programs in Mexican potato producing areas, in order to minimize the risk of spreading pathogenic seed-tuber-borne inoculum. The fact that every S. acidiscabies strain isolated from different locations in the El Fuerte Valley (Sinaloa) was 100 % identical at the molecular level supports previous observations that the 16S rRNA gene is highly conserved in Streptomyces species (Anderson and Wellington 2001). However, our 16S rDNA phylogeny analysis indicates that the S. acidiscabies strains that cause PCS in Sinaloa cluster with pathogenic S. acidiscabies strains from other parts of the world.
Although S. acidiscabies has been reported in soil at pH 4.5–5.5 (Loria et al. 2006), common scab has been observed in Sinaloan commercial potato fields at pH 7.0–7.2. Previous studies found that the optimum growth of this pathogen as evidenced by mycelium density and rate of colony development occurs on pH 7.0 (Lambert and Loria 1989b); this may explain why S. acidiscabies has become an important pathogen in potato in Sinaloa where soil pH ranges from 7.0 to 7.2. This soil pH range is identical to what we have used here to test the pathogenicity of the ten S. acidiscabies strains on potato, radish, carrot and beet under greenhouse conditions, implying that S. acidiscabies is acid-tolerant rather than acidophilic (Lambert and Loria 1989b). Until now, S. acidiscabies has only been observed on potato; here, we have demonstrated that this species could also infect radish, carrot and beet, as previously reported (Goyer and Beaulieu 1997). Nevertheless, the incidence and severity of S. acidiscabies observed in commercial potato fields and its effect on radish, carrot and beet in pot trials has not yet been reported in Mexico. The ten S. acidiscabies strains that we isolated from scabby potato tubers caused identical symptoms in progeny tubers under greenhouse conditions. In our study, every strain was highly pathogenic on radish, in agreement with previous studies in which many Streptomyces isolates were pathogenic on this crop (Levick et al. 1985; Wanner 2004). Our results therefore indicate that radish may be used in the absence of potato to test the pathogenicity of S. acidiscabies from Sinaloa, as previously proposed (Wanner 2004). Furthermore, our results demonstrate that the pathogenicity of the ten strains is not limited to potato, as previously reported for S. acidiscabies (Lambert 1991) and other Streptomyces species (Goyer and Beaulieu 1997; Janse 1998; Levick et al. 1985; Tashiro et al. 1990). This implies that radish, carrot and beet must not be grown in fields where potato scab has occurred in previous growing seasons. Differences in virulence among the strains from Sinaloa were mainly observed on carrot, where two isolates were not pathogenic.
Our in vitro pot and field trials demonstrate that the fungicide fluazinam was highly effective against S. acidiscabies, whereas mancozeb and benzothiazole were less effective. The in vitro inhibition effect of S. acidiscabies by fluazinam persisted through the pot trials and field experiments. Our results are in agreement with previous studies in which fluazinam and mancozeb were used to control common scab caused by Streptomyces sp. (Pung and Cross 2000; Wilson et al. 1999). The same fungicides applied in field experiments at seeding time and 45 days after planting reduced common scab severity caused by S. scabies in the Mayo Valley (Leyva-Mir et al. 2014). In previous studies (data not shown), we reported that spraying seed tubers with a combination of mancozeb + gentamicin sulfate + oxytetracycline hydrochloride for one minute inactivates 95–98 % of scab lesions with a diameter of 0.1–0.7 cm. In the current field experiments, seed pieces were not treated by dressing, but were instead sprayed on the ground before they were covered with soil at seeding time. In our study, S. acidiscabies was involved on in vitro, greenhouse and field trials. The results on chemical control were consistent in contrast with previous studies, where disease control was inconsistent (Davis et al. 1976; Wilson et al. 1999) and the identity of the causal agent PCS was undetermined (Wilson et al. 1999). However, additional studies should be carried out in commercial potato fields to validate the results under these conditions. Our results indicate that fluazinam was highly effective against PCS with an IC50 ranging from 18.5 to 56.0 ppm. The sensitivity of a wide number of S. acidiscabies strains to fluazinam should be tested not only in Sinaloa, but also in other potato growing regions in Mexico; this will allow the establishment of a sensitivity base line of the pathogen to the fungicide, and would be informative with regards to the subsequent response of pathogen population under field conditions. Field trials will now be conducted to assess the efficacy of combining potato seed dressing with spraying the furrow at seeding time in the control of common scab caused by S. acidiscabies.
It is generally considered that populations of Streptomyces spp. that cause scab transmitted by potato seed tuber are likely to be far outnumbered by the inoculum in the field soil (Lapwood 1972). Accordingly, a high incidence of scab has occurred in fields in Sinaloa where potatoes have not been grown for years (or where they were never grown), increasing the likelihood that the potato seed is infected with Streptomyces. This possibility is supported by previous reports that have noted the importance of seed tubers and soil-borne inoculum, which can also depend on locality, soil type, pathogen population and cultural practice (Wilson et al. 1999). We present here the first report to implicate a pathogenic role for S. acidiscabies on potato and other vegetable crops in Mexico. In this study, we examined a single control measure in which fluazinam was the most effective fungicide against common scab. Nevertheless, there are indications that a combination of control measures could provide a more substantial control, although this will require studies in which control factors are integrated to determine their effectiveness (Mishra and Srivarastava 2001; Stead and Wale 2004; Wiechel and Crump 2010).
References
Anderson, A.S., and E.M. Wellington. 2001. The taxonomy of Streptomyces and related genera. International Journal of Systematic and Evolutionary Microbiology 51: 797–814.
Bjor, T., and L. Roer. 1980. Testing the resistance of potato varieties to common scab. Potato Research 23: 33–47.
Bouchek-Mechiche, K., L. Gardan, P. Norman, and B. Jouan. 2000. DNA relatedness among strains of Streptomyces pathogenic to potato in France: descrption of three new species, S. europeiescabiei sp.nov. and S. stelliscabiei sp. nov. associated with common scab and S. reticuliscabiei associated with netted scab. International Journal of Systematic and Evolutionary Microbiology 50: 91–99.
Bukhalid, R.A., T. Takeuchi, D. Labeda, and R. Loria. 2002. Horizontal transfer of the plant virulence gene, nec1, and flanking sequences among genetically distinct Streptomyces strains in the Diastatochromogenes cluster. Applied and Environmental Microbiology 68: 738–744.
Chen, W.P., and T.T. Kuo. 1993. A simple and rapid method for the preparation of gram-negative bacterial genomic DNA. Nucleic Acids Research 21: 22–60.
Conover, W.J. 1999. Practical nonparametric statistics. New York: John Wiley & Sons, Inc..
Cullen, D.W., and A.K. Lees. 2007. Detection of the nec1 virulence gene and its correlation with pathogenicity in Streptomyces species on potato tubers and in soil using conventional and real-time PCR. Journal of Applied Microbiology 102: 1082–1094.
Davis, J.R., and R.H. Callihan. 1971. Effects of fungicide treatment on tuber quality, scab and Rhizoctonia control of russet Burbank potato. American Potato Journal 48: 295–308.
Davis, J.R., G.M. McMaster, R.H. Callihan, F.H. Nissley, and J.J. Pavek. 1976. Influence of soil moisture and fungicide treatments on common scab and mineral content of potatoes. Phytopathology 66: 228–233.
De, B.K., and P.C. Sengupta. 1993. Chemical control of common scab of potato. Journal of the Indian Potato Association 20: 273–274.
Doering-Saad, C., P. Kampfer, S. Manulis, G. Kritzman, J. Schneider, J. Zakrzewskaczerwinska, H. Schrempf, and I. Barash. 1992. Diversity among Streptomyces strains causing potato scab. Applied and Environmental Microbiology 58: 3932–3940.
Edgar, R.C. 2004. MUSCLE: multiple sequence alignment with high accuracy and high throughput. Nucleic Acids Research 32: 1792–1797.
Faucher, E., E. Paradis, C. Goyer, N.C. Hodge, R. Hogue, R.E. Stall, and C. Beaulieu. 1995. Characterization of Streptomyces causing deep-pitted scab of potato in Québec, Canada. International Journal of Systematic Bacteriology 45: 222–225.
Felsenstein, J. 1985. Confidence limits on phylogenies: an approach using the bootstrap. Evolution 39: 783–791.
Gomez, K.A., and Gomez, A.A. 1984. Statistical procedures for agricultural research. Second Edition. United States of America. John Wiley Sons Inc. 680 p.
Goyer, C., and C. Beaulieu. 1997. Host range of Streptomycete strains causing common scab. Plant Disease 81: 901–904.
Healy, F.G., and D.H. Lambert. 1991. Relationships among Streptomyces spp causing potato scab. International Journal of Systematic Bacteriology 41: 479–482.
Hill, J., and G. Lazarovits. 2005. A mail survey of growers to estimate potato common scab prevalence and economic loss in Canada. Canadian Journal of Plant Pathology 27: 46–52.
Hooker, W.J. 1981. Compendium of potato disease, 33–34. St. Paul: American Phytopathological Society.
Hosny, M., K.A.M. Abo-Elyousr, M.R. Asran, and F.A. Saead. 2014. Chemical control of potato common scab disease under field conditions. Archives of Phytopathology and Plant Protection 47: 2193–2199.
Janse, J.D. 1998. A Streptomyces species identified as the cause of carrot scab. Netherlands Journal of Plant Pathology 94: 303–306.
Kimura, M. 1980. A simple method for estimating evolutionary rates of base substitutions through the comparative studies of sequence evolution. Journal of Molecular Evolution 16: 111–120.
Kirk, W.W. 2015. Introduction to 2013 symposium on bacterial diseases of potatoes. American Journal of Potato Research 92: 215–217.
Koenraad, F.M., B. Tierens, M.B. Thomma, S. Jurgen, K. Kistner, A. Porzel, B. Mauch-Mani, P.A. Cammue, and W.F. Broekaert. 2001. Study of the role of antimicrobial glucosinolate-derived isothiocyanates in resistance of Arabidopsis to microbial pathogens. Plant Physiology 125: 1688–1699.
Kreuze, J.F., S. Soumalainem, L. Paulin, and J.P.T. Valkonen. 1999. Phylogenetic analysis of 16S rRNA genes and PCR analysis of the nec1 gene from Streptomyces spp. causing common scab, pitted scab and netted scab in Finland. Phytopathology 89: 462–469.
Lambert, D.H. 1991. First report of additional hosts for the acid scab pathogen Streptomyces acidiscabies. Plant Disease 75: 750.
Lambert, D.H., and R. Loria. 1989a. Streptomyces scabies sp. nov., nom. rev. International Journal of Systematic Bacteriology 39: 387–392.
Lambert, D.H., and R. Loria. 1989b. Streptomyces acidiscabies sp. nov. International Journal of Systematic Bacteriology 39: 393–396.
Lapwood, D.H. 1972. The relative importance of weather, soil and seed-borne inoculum in determining the incidence of common scab (S. scabies) in potato crops. Plant Pathology 21: 105–108.
Lehtonen, M.J., H. Rantala, J.F. Kreuse, H. Bang, L. Kuisma, P. Koski, E. Virtanen, K. Vihlman, and J.P.T. Valconen. 2004. Occurrence and survival of potato scab pathogens (Streptomyces scabies) on tuber lesions: quick diagnosis based on PCR-based assay. Plant Pathology 53: 280–287.
Lerat, Y., A.M. Simao-Beaunoir, and C. Beaulieu. 2009. Genetic and physiological determinants of Streptomyces scabies pathogenicity. Molecular Plant Pathology 10: 579–585.
Levick, D.R., T.A. Evans, C.T. Stephens, and M.L. Lacy. 1985. Etiology of radish scab and its control through irrigation. Phytopathology 75: 568–572.
Leyva-Mir, S.J., F. Garay-Lizarraga, O.G. Alvarado-Gomez, L.E. Castillo-Marquez, and J.M. Tovar-Pedraza. 2014. Detección y control de Streptomyces scabies en tubérculos de papa (Solanum tuberosum L.) en el valle del Mayo, Sonora, México. Chilean Journal of Agriculture & Animal Science, ex Agro-Ciencia 30: 5–13.
Little, T.M., and F.J. Hills. 1973. Agricultural experimentation and analysis, 350. New York: John Wiley and Sons.
Locci, R. 1994. Actinomycetes as plant pathogens. European Journal of Plant Pathology 100: 179–200.
Loria, R., R.A. Bukhalid, B.A. Fry, and R.R. King. 1997. Plant pathogenicity in the genus Streptomyces. Plant Diseases 81: 836–846.
Loria, R., J. Kers, and M. Joshi. 2006. Evolution of plant pathogenicity in Streptomyces. Annual Review of Phytopathology 44: 469–487.
Manzer, F.E., G.A. McIntyre, and D.C. Merriam. 1977. A new potato scab problem in Maine. Maine Life Science Agriculture Experiment Station Bulletin. 85: 1–24.
Mishra, K.K., and J.S. Srivastava. 2001. Screening potato cultivars for common scab of potato in naturally infested soil. Potato Research 44: 19–24.
Mishra, P.K., D. Mishra, J.K. Dhal, and P.K. Chhotaray. 1991. Control of common scab of potato by seed tuber treatment. Orissa Journal of Agriculture Research 4: 120–121.
Miyajima, K., F. Tanaka, T. Takeuchi, and S. Kuninaga. 1998. Streptomyces turgidiscabies sp. nov. International Journal of Systematic Bacteriology 48: 495–502.
Monciardini, P., M. Sosio, L. Cavaletti, C. Chiocchini, and S. Donadio. 2002. New PCR primers for the selective amplification of 16S rDNA from different groups of actinomycetes. FEMS Microbiology Ecology 42: 419–429.
Park, D.H., Y.M. Yu, J.S. Kim, J.M. Cho, J.H. Hur, and C.K. Lim. 2003. Characterization of Streptomycetes causing potato common scab in Korea. Plant Disease 87: 1290–1296.
Pung, H., and S. Cross. 2000. Common scab incidence on seed potatoes, and seed-borne disease control. Conference Proceedings of potatoes. 31th July-3th August. Adelaide, South Australia.
Rete-Corral, A. 2011. Tesis de Maestría. Centro Interdisciplinario de Investigación para el Desarrollo Integral Regional. Sinaloa: Guasave.
Saitou, N., and M. Nei. 1987. The neighbor-joining method: a new method for reconstructing phylogenetic trees. Molecular Biology and Evolution 4: 406–425.
Schaad, N.W., J.B. Jones, and W. Chun. 2001. Laboratory guide for identification of plant pathogenic bacteria, 164 p. St. Paul. Third edition: APS Press.
Sebaugh, J.L. 2011. Guidelines for accurate EC50/IC50 estimation. Pharmaceutical Statistics 10: 128–134.
Shirling, E.B., and D. Gottlieb. 1966. Methods for characterization of Streptomyces species. International Journal of Systematic Bacteriology 16: 313–340.
Singh, H., and P.S. Soni. 1987. Chemical control of common scab of potato. Plant Disease Research 2: 77–79.
Slack, S.A. 1991. A look at potato leafroll virus and potato virus Y: past, present, future. Badger Common Tater 43: 16–21.
Song, J., S.-C. Lee, J.-W. Kang, H.-J. Baek, and J.-W. Suh. 2004. Phylogenetic analysis of Streptomyces spp. isolated from potato scab lesions in Korea on the basis of 16S rRNA gene and 16S–23S rDNA internally transcribed spacer sequences. International Journal of Systematic and Evolutionary Microbiology 54: 203–209.
Stead, D., and S. Wale. 2004. Non-water control measures for common scab. Research Review. British Potato Council R248: 49pp.
Takeuchi, T., H. Sawada, F. Tanaka, and I. Matsuda. 1996. Phylogenetic analysis of Streptomyces spp. causing potato scab based on 16S rRNA sequences. International Journal of Systematic Bacteriology 46: 476–479.
Tamura, K., G. Stecher, D. Peterson, A. Filipski, and S. Kumar. 2013. MEGA6: molecular evolutionary genetics analysis version 6.0. Molecular Biology and Evolution 30: 2725–2729.
Tashiro, N., K. Miyashita, and T. Suzui. 1990. Taxonomic studies on the Streptomyces species isolated as causal organisms of potato common scab. Annals of the Phytopathological Society of Japan 56: 73–82.
Wanner, L.A. 2004. Field isolates of Streptomyces differ in pathogenicity and virulence on radish. Plant Disease 88: 785–796.
Wanner, L.A. 2007. A new strain of Streptomyces causing common scab in potato. Plant Disease 91: 352–359.
Wanner, L.A. 2009. A patchwork of Streptomyces species isolated from potato common scab lesions in North America. American Journal of Potato Research 86: 247–264.
Wanner, L.A., and W.W. Kirk. 2015. Streptomyces-from basic microbiology to role as a plant pathogen. American Journal of Potato Research 92: 236–242.
Wiechel, T.J., and Crump, N.S. 2010. Soil nutrition and common scab disease of potato in Australia. 19th world Congress of soil science, soil solutions for a changing world. 1–6 August 2010. Brisbane, Austalia. 237-240.
Wilson, C.R., L.M. Ramson, and B.M. Pemberton. 1999. The relative importance of seed-borne inoculum to common scab disease of potato and the efficacy of seed tuber and soil treatments for disease control. Journal of Phytopathology 147: 13–18.
Author information
Authors and Affiliations
Corresponding author
Rights and permissions
About this article
Cite this article
Santos-Cervantes, M.E., Felix-Gastelum, R., Herrera-Rodríguez, G. et al. Characterization, Pathogenicity and Chemical Control of Streptomyces acidiscabies Associated to Potato Common Scab. Am. J. Potato Res. 94, 14–25 (2017). https://doi.org/10.1007/s12230-016-9541-5
Published:
Issue Date:
DOI: https://doi.org/10.1007/s12230-016-9541-5